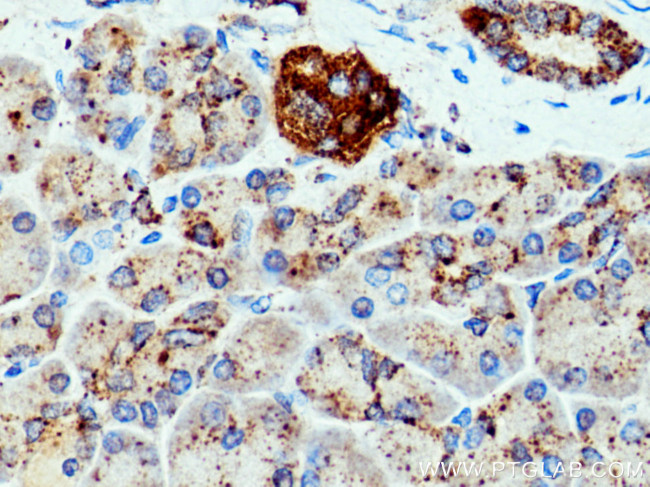
CTSZ Antibody in Immunohistochemistry (Paraffin) (IHC (P))
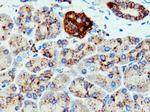
CTSZ Antibody in Immunohistochemistry (Paraffin) (IHC (P))

Search
Proteintech
CTSZ Polyclonal Antibody
{{$productOrderCtrl.translations['antibody.pdp.commerceCard.promotion.promotions']}}
{{$productOrderCtrl.translations['antibody.pdp.commerceCard.promotion.viewpromo']}}
{{$productOrderCtrl.translations['antibody.pdp.commerceCard.promotion.promocode']}}: {{promo.promoCode}} {{promo.promoTitle}} {{promo.promoDescription}}. {{$productOrderCtrl.translations['antibody.pdp.commerceCard.promotion.learnmore']}}
产品信息
16578-1-AP
种属反应
宿主/亚型
分类
类型
抗原
偶联物
形式
浓度
规格
纯化类型
保存液
内含物
保存条件
运输条件
产品详细信息
Aliquoting is unnecessary for -20°C storage.
靶标信息
The protein encoded by this gene is a lysosomal cysteine proteinase and member of the peptidase C1 family. It exhibits both carboxy-monopeptidase and carboxy-dipeptidase activities. The encoded protein has also been known as cathepsin X and cathepsin P. This gene is expressed ubiquitously in cancer cell lines and primary tumors and, like other members of this family, may be involved in tumorigenesis.
仅用于科研。不用于诊断过程。未经明确授权不得转售。
生物信息学
蛋白别名: carboxypeptidase LB; cathepsin B2; cathepsin IV; Cathepsin P; Cathepsin X; Cathepsin Y; Cathepsin Z; cathepsin Z1; cysteine protease of the papain family; cysteine-type carboxypeptidase; lysosomal carboxypeptidase B; precursor of a cysteine protease; preprocathepsin P; unnamed protein product
基因别名: AI787083; AU019819; CATX; CTSX; Ctsy; CTSZ; D2Wsu143e
UniProt ID: (Human) Q9UBR2, (Mouse) Q9WUU7, (Rat) Q9R1T3
Entrez Gene ID: (Human) 1522, (Mouse) 64138, (Rat) 252929